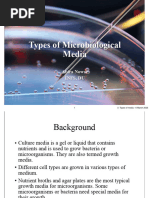

Elephant Toothpaste
Teacher’s Instructions
Teaching objectives:
Students will observe several examples of chemical and physical reactions
Students will carry out the decomposition reaction of hydrogen peroxide
Students will describe and illustrate the changes of the hydrogen peroxide
chemical reaction
Recommended Grades: K-5
Estimated Time: about an hour
Key concepts and terms:
Reaction: a transformation or change
Chemical Reaction: a process in which one substance is converted into a new substance
with new properties
Physical Reaction: a process in which a substance changes in size, shape or color but
does not change in composition.
Catalyst: A substance that alters the speed of a chemical reaction
Procedure:
1. Over all tables, drape trash can bags to try and prevent excess mess. At each
student’s seat, place a cake pan or plastic bin, an empty soda bottle with its cap, a
closed container with ½ cup hydrogen peroxide, a container with 1 tsp dry active
yeast, and a spoon. At each table set out a container of food coloring.
2. Ask the class to give examples of reactions. Tell them baking a cake is a kind of
reaction, and so is blowing out a candle. Give examples of both a chemical and a
physical reaction. If you want, play the Chemical vs. Physical Game (See
Supplementary Exercises).
3. Tell the class that they will be working with a chemical called Hydrogen
Peroxide, or H2O2. This is a fairly non-toxic chemical, but they should be wearing
goggles. Show them a picture of the molecule, and how it breaks down with very
slowly into water and oxygen.
4. Ask the class what would happen if the hydrogen peroxide turned into water and
oxygen VERY fast. Tell them that a reaction helper called a catalyst can help a
reaction speed up.
5. If there is room in the class, hand out the worksheet.
6. Tell everyone to carefully open the hydrogen peroxide container. Using a funnel,
have the students carefully pour the liquid into the bottles. After pouring, tell the
students to put caps back on their bottles.
Katy Harmon
January 2008
� 7. Tell students they can choose a color food dye to put in their bottles. Let them
carefully squeeze 4-5 drops into the bottle if they want to. Help them add one
squirt of Dawn dish detergent, and then have them put the caps back on their
bottles.
8. Heat up the water. Plan on bringing extra, because some may evaporate. The
water doesn’t have to boil, but it should be just warm enough to dissolve yeast
(and not hot enough to burn anyone!)
9. Distribute ~10 mls (2 tsp) of water to each student in their yeast container. Tell
them to stir the yeast with the spoons until it looks smooth and not lumpy. If
students need something to do, have them gently swirl their bottle. Tell them not
to shake it (the reaction won’t work well if they do). Wait until everyone is ready.
10. Explain to the class what everyone is going to do. Tell them not to do anything
until you say ‘Go!’. Tell the students they will uncap their bottles, pour the brown
solution (the helper or catalyst) into their bottles, and wait. Tell them they can
touch the bottle and articulate their observations (the reaction is exothermic, so
the bottle should feel warm.) If there is a sink and plenty of paper towels in the
room, tell them they can touch the foam gently. Ask everyone if they understand
what they are going to do. If you feel confident they are ready and you are ready,
say “Ready? Go!”
11. Ask students to talk about what they see as it’s happening. What does the foam
feel like? Is there anything left in the bottle?
12. Get students to participate in clean up activities, then have an assistant continue
to clean up while you move students to new tables or to a sit-down area on the
floor.
13. Time permitting, have students draw a sketch of the “Elephant Toothpaste.” Ask
them what they thought happened. Do they think it was a chemical or a physical
reaction? Hand out the Elephant Toothpaste recipes so they can try the experiment
at home with their families.
Why it works:
Hydrogen peroxide is an oxidizing agent. Over time, it is converted to water and oxygen
in a decomposition reaction according to the following formula:
2 H2O2 --> 2 H2O + O2
However, this reaction goes very slowly. It is, however, favorable, and is
exothermic: it releases some heat as it takes place. Reactions can speed up by
adding heat, adding more reaction materials, or adding a catalyst. In the case of
the Elephant’s Toothpaste, the yeast is a catalyst which makes the hydrogen
peroxide release the oxygen faster. The reaction is exothermic, meaning that heat is
released as the reaction proceeds. The detergent is added as a surfactant: it allows the
catalytic yeast to react with as much of the hydrogen peroxide as
possible.
Katy Harmon
January 2008
�Supplementary exercises
Chemical vs. Physical Game: Make up some cards ahead of time that depict chemical or
physical changes. Show each card to the class and ask them to guess if the change is
chemical or physical.
Physical reaction: Bring in some snow from outside, or ice from a freezer. How did the
water change? What color is snow? What color is water? Freezing and melting are
examples of physical reactions.
Chemical reaction: Take an empty bottle and add vinegar to it (about a cup). Wrap about
2 tbsp. of baking soda loosely in aluminum foil, stick it in the bottle, and put the cork in.
Keep the bottle pointing upward, and shake vigorously. Kapow! This is an example of a
chemical reaction.
REFERENCES:
1. Elephant’s Toothpaste – Kid Friendly. Online:
<http://www.stevespanglerscience.com/experiment/elephants-toothpaste>
Katy Harmon
January 2008
� Elephant Toothpaste
Materials List
20-30 empty plastic soda bottles, 24 oz. or smaller, with caps
3% Hydrogen peroxide: 120 mls (about ½ cup) per child
Dawn ultra concentrated dishwashing detergent (works the best, though others
can be substituted)
Sealable containers to hold hydrogen peroxide
Containers to hold yeast mixture
Yeast: 1 tsp per child
Water: 2 tsp per child
Plastic spoons
Plastic funnels
Heating device for water (microwave, hot plate, electric kettle)
20-30 Cake pans or large plastic bins
Food coloring
Glitter
Garbage bags
Goggles for children
Age-appropriate worksheets (below)
Katy Harmon
January 2008
� Elephant Toothpaste
Recipe
You can make elephant toothpaste at home!
You will need:
3% Hydrogen Peroxide
An empty soda bottle with a cap (16 oz. or smaller)
Dawn dishwashing detergent
A large cake pan
Yeast
Warm water (not boiling)
Food coloring
Smock or lab coat
Goggles
An adult
A place it’s okay to make a mess!
Procedure
1. First, put on your smock or lab coat and goggles. Always be careful when
doing chemistry, even in the kitchen.
2. Set the empty soda bottle inside the cake pan.
3. Have an adult help you get ½ cup of the hydrogen peroxide and pour it
into the empty soda bottle.
4. Add 4-5 drops of food coloring and one squirt of the dishwashing
detergent. Cap the bottle tightly.
5. Don’t shake the bottle, but swirl it around gently so that the ingredients
can mix.
6. Mix 1 tsp of yeast with 2 tsp hot water until it dissolves and there are no
more lumps.
7. Uncap the soda bottle and quickly pour in the yeast mixture. Yikes! The
bottle will be warm from the reaction, and the foam is safe to touch (it’s
just oxygen bubbles and soap).
8. Clean up! Make sure you wash your hands well before your next activity.
Name_______________
Date________________
Katy Harmon
January 2008
� What did you observe when the reaction happened?
………………………………………………………………………………
…………………………..
………………………………………………………………………………
…………………………..
Draw a picture below of what you saw in your bottle:
Elephant Toothpaste
Recipe
Katy Harmon
January 2008
�Thrill your friends…scare your siblings…try making elephant toothpaste at
home!
You will need:
3% Hydrogen Peroxide
An empty soda bottle with a cap (16 oz. or smaller)
Dawn dishwashing detergent
A large cake pan
Yeast
Warm water (not boiling)
Food coloring
Smock or lab coat
Goggles
A place it’s okay to make a mess
Procedure
1. First, put on your smock or lab coat and goggles. Always be careful when
doing chemistry.
2. Set the empty soda bottle inside the cake pan.
3. Get ½ cup of the hydrogen peroxide and pour it into the empty soda bottle.
This is toxic stuff, so don’t fool around with it too much.
4. Add 4-5 drops of food coloring and one squirt of the dishwashing
detergent. Cap the bottle tightly.
5. Don’t shake the bottle, but swirl it around gently so that the ingredients
can mix.
6. Mix 1 tsp of yeast with 2 tsp hot water until it dissolves and there are no
more lumps.
7. Uncap the soda bottle and quickly pour in the yeast mixture. The bottle
will be warm from the reaction, and the foam is safe to touch (it’s just
oxygen bubbles and soap).
Name_______________
Date________________
Elephant Toothpaste
What did you observe when the reaction happened?
Katy Harmon
January 2008
�………………………………………………………………………………
…………………………..
………………………………………………………………………………
…………………………..
Which ingredient caused the decomposition of H2O2 to go faster?
………………………………………………………………………………
…………………………..
How else could you make your reaction go faster?
………………………………………………………………………………
…………………………..
………………………………………………………………………………
…………………………..
………………………………………………………………………………
…………………………..
Was this a chemical or physical reaction? (circle one)
CHEMICAL PHYSICAL
Name___________________
Date____________________
Katy Harmon
January 2008
� Elephant Toothpaste: Worksheet 1
There’s a lot of chemistry vocabulary we’ll be going over today. Fill out this worksheet
and bring it to Katy or Liz at the end. If everything’s correct, they’ll have a small prize
for you. Good Luck!
1. A chemical reaction is….
………………………………………………………………………………………………
………………………………………………………………………………………………
2. Draw or describe an example of a chemical reaction below:
3. A physical reaction is….
………………………………………………………………………………………………
………………………………………………………………………………………………
4. Draw or describe an example of a physical reaction:
1
5. True or False:
____ Acids react with bases
____Vinegar is a base
____ Alka-seltzer reacts with acetic acid
Katy Harmon
January 2008
�____An acid-base reaction is a chemical reaction
6. Which one of these clues could prove a scientific experiment involves a chemical
reaction? (circle at least one)
Bill Nye does the experiment You see a color change
You smell a gas that is released Your teacher tells you it’s a chemical
reaction
7. How could you speed up a reaction? List just one way.
………………………………………………………………………………………………
………………………………………………………………………………………………
8. What catalyst did we use in the Elephant Toothpaste demonstration?
………………………………………………………………………………………………
………………………………………………………………………………………………
9. (Extra Credit) Why is chemistry so awesome?
………………………………………………………………………………………………
………………………………………………………………………………………………
………………………………………………………………………………………………
2
Katy Harmon
January 2008